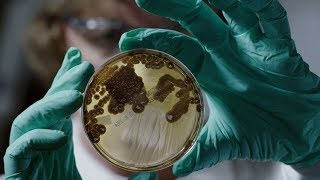
Trailer Preview Image

Resistance Fighters – The Global Antibiotics Crisis streaming: where to watch online?
You can buy "Resistance Fighters – The Global Antibiotics Crisis" on Apple TV as download or rent it on Apple TV online.
There aren't any free streaming options for Resistance Fighters – The Global Antibiotics Crisis right now. If you want know when it is streaming for free, click 'Free' in the filters above and hit the notification bell.